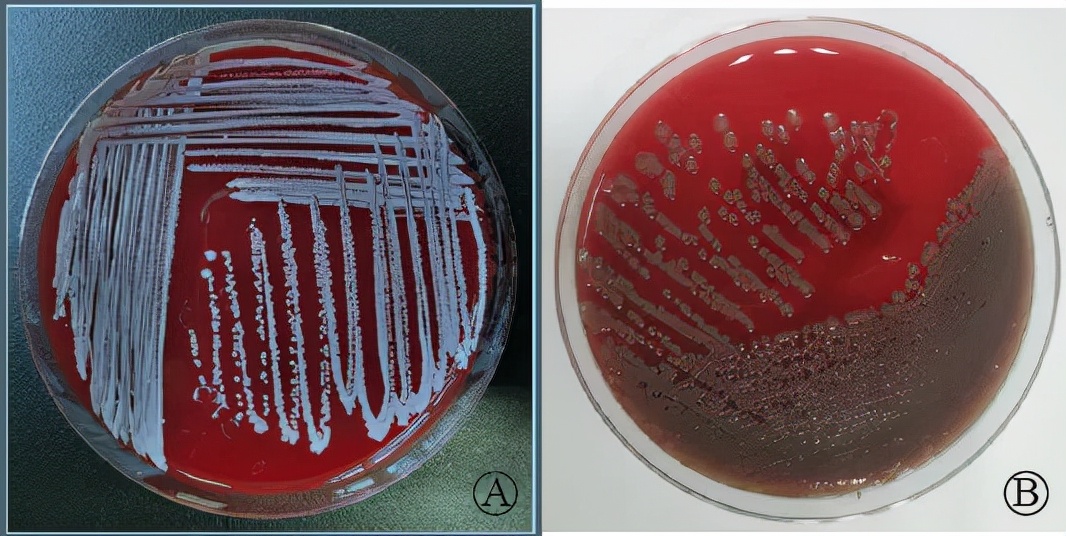
手术切口感染的主要病原菌是 (骨科一类切口感染原因分析)

来源:中华肩肘外科电子杂志 2021年8月第9卷第3期
作者:张宏侠,葛冰磊,左才红,李军,张庆,张财义,黄照国,陈健
医院:宣城市人民医院
摘要
目的: 对骨科Ⅰ类切口手术部位感染的病原菌进行分析研究,为临床合理运用抗生素和控制手术部位感染提供参考。
方法: 回顾性分析我院2010年1月至2020年12月骨科Ⅰ类切口手术部位感染送检的150份标本检测结果,对病原菌分布和耐药性进行统计学分析。
结果: 150份切口分泌物标本中122份培养出细菌,细菌培养阳性率81.33%,其中革兰阳性菌占68.85%,革兰阴性菌占31.15%。检出率最高的革兰阳性菌为金黄色葡萄球菌(62株),其次为溶血性葡萄球菌(9株)。金黄色葡萄球菌对环丙氟哌酸(10.71%)、左氧氟沙星(7.14%)、利福平(7.14%)耐药率较低。检出率最高的革兰阴性菌为阴沟肠杆菌(17株),其次为大肠埃希菌(9株),阴沟肠杆菌对左氧氟沙星、头孢他啶、阿米卡星尚无耐药菌株。
结论: 骨科Ⅰ类切口手术部位感染的主要病原菌为金黄色葡萄球菌,其次为阴沟肠杆菌,在药敏报告出来前,可以选用耐药率较低的抗生素如喹诺酮类联合利福平进行抗感染治疗,然后根据药敏结果及时调整。
关键词:骨科;Ⅰ类切口;手术部位感染;病原菌
手术部位感染(surgical site infections, SSI)是外科围手术期发生在切口、手术深部器官或腔隙的感染,是除泌尿道、肺部和血液感染外院内感染最常见的部位之一。SSI对于患者的身体健康会造成非常严重的影响,甚至还会威胁到患者的生命安全。除了对患者的负面影响外,SSI还会给医疗系统带来巨大的经济负担[1]。有研究资料统计分析表浅的SSI每例治疗费可高达400美元,而深层SSI每例治疗费可高达30000美元[2]。骨科手术后SSI是一种严重的并发症,发病率高,经济负担重[3-4]。由于骨科住院患者的手术切口以Ⅰ类切口(清洁手术)为主,因此对骨科住院患者Ⅰ类切口SSI送检标本的病原菌分布和耐药率情况进行统计分析,能为临床治疗提供参考,指导抗菌药物的合理使用。本研究回顾性分析了我院2010~2020年骨科Ⅰ类切口SSI的送检标本病原菌检测结果,报道如下。
对象与方法
一、研究对象
分析我院2010~2020年骨科Ⅰ类切口SSI送检的150份标本检测结果,同一患者同一手术部位多次送检标本检测结果仅取第一次检测结果。
二、研究方法
采用血平皿法和麦康凯琼脂培养,采用VITEK-2compact微生物全自动分析仪进行细菌鉴定及药敏试验,采用纸片扩散法,根据美国临床与实验室标准协会的标准判读药敏结果。选用大肠埃希菌ATCC25922、铜绿假单胞菌ATCC27853及金黄色葡萄球菌ATCC25923、ATCC29213作为质控菌株。细菌培养、鉴定与药敏实验:(1)细菌培养,形成菌落(图1);(2)革兰染色,将细菌分为两大类,凡被染成紫色的细菌为革兰阳性菌;染成红色的细菌为革兰阴性菌(图2);(3)显微镜镜检细菌形态(图3)。(4)采用微生物分析仪进行细菌鉴定及药敏试验,判读药敏结果。
图1 细菌培养:球菌菌落

图2 革兰染色:革兰阳性菌(A),革兰阴性菌(B)

图3 显微镜镜检:革兰阳性球菌(A),革兰阴性杆菌(B)
三、统计学分析
用WHONET5.6软件统计骨科Ⅰ类切口SSI送检标本中的病原菌分布(%)及耐药率(%)。
结果
一、细菌培养阳性率
纳入研究的骨科Ⅰ类切口SSI的150份送检标本中122份培养出细菌,细菌培养阳性率81.33%,其中革兰阳性菌占68.85%,革兰阴性菌占31.15%,见表1。
二、病原菌分布
革兰阳性菌84株,依次为金黄色葡萄球菌62株,溶血性葡萄球菌9株,人葡萄球菌人亚种和表皮葡萄球菌分别为5株和4株,华纳葡萄球菌和头状葡萄球菌各2株。革兰阴性菌38株,依次为阴沟肠杆菌17株,大肠埃希菌9株,鲍曼不动杆菌、产气肠杆菌、斯图普罗威登斯菌、肺炎克雷伯菌、奇异变形杆菌和铜绿假单胞菌各2株,见表1。
表1 送检标本病原菌分布

三、细菌对抗菌药物的耐药率
检出率最高的革兰阳性菌为金黄色葡萄球菌(62株),其中耐甲氧西林金黄色葡萄球菌(methicillin-resistant Staphylococcus aureus, MRSA)有9株。金黄色葡萄球菌对环丙氟哌酸(10.71%)、左氧氟沙星(7.14%)、利福平(7.14%)耐药率较低,对甲氧苄氨嘧啶/磺胺、利奈唑胺、达托霉素、万古霉素尚无耐药菌株。主要革兰阳性菌对常用抗菌药物的耐药率见表2。
表2 主要革兰阳性菌对常用抗菌药物的耐药率(%)

检出率最高的革兰阴性菌为阴沟肠杆菌(17株)。阴沟肠杆菌对头孢吡肟(14.29%)、环丙氟哌酸(14.29%)、庆大霉素(14.29%)耐药率较低,对左氧氟沙星、头孢他啶、厄他培南、亚胺培南、美洛培南、阿米卡星、哌拉西林/他唑巴坦尚无耐药菌株。主要革兰阴性菌对常用抗菌药物的耐药率见表3。
讨论
近年来,伴随社会经济的快速发展,车祸伤和高空坠落伤所致高能量损伤患者越来越多。同时随着中国进入老龄化社会[5],低能量损伤所致老年骨折患者也越来越多。接受内固定手术治疗患者不断增多,由于患者伤情多变以及老年患者合并症多,造成术后SSI患者数量也在不断增加[6]。既往文献报道骨科SSI比率可能超过3%[7]。
本研究结果显示,骨科Ⅰ类切口SSI送检标本细菌培养阳性率为81.33%。造成细菌培养阳性率低的可能原因:(1)临床标本采集不规范;(2)标本运送未合理保存或未及时运送;(3)检验人员经验不足,对细菌的检出也有一定影响。临床应重视细菌培养标本的采集[8]。从细菌培养结果来看,骨科Ⅰ类切口SSI的病原菌以革兰阳性菌为主,占68.85%,主要为金黄色葡萄球菌(62株,占50.82%),这和先前文献报道一致[9],其中MRSA有9株,这增加了治疗难度。革兰阴性菌占31.15%,主要为阴沟肠杆菌(17株,占13.93%),还有9株产超广谱β-内酰胺酶的大肠埃希菌。
表3 主要革兰阴性菌对常用抗菌药物的耐药率(%)

从药敏结果来看,金黄色葡萄球菌对临床常用抗生素氨苄西林、青霉素、红霉素、克林霉素的耐药率>39%,可以选用左氧氟沙星、利福平进行治疗(耐药率<10%)。对于MRSA感染,使用万古霉素或达托霉素进行治疗,目前尚无耐药菌株。阴沟肠杆菌对氨苄西林、头孢唑啉、头孢西丁、阿莫西林/克拉维酸钾、头孢噻肟、头孢曲松的耐药率>40%,可以选用左氧氟沙星、头孢他啶、阿米卡星进行治疗,尚无耐药菌株。对于多种细菌联合感染和需氧菌及厌氧菌的混合感染,可以选用厄他培南、亚胺培南、美洛培南进行治疗。
引起骨科Ⅰ类切口SSI的主要危险因素:(1)手术时间:Boddapati等[10]研究发现关节镜手术时间长增加了SSI的风险,手术时间>45min时,浅表性SSI增加,这可能是因为手术时间长增加了微生物(如*疮痤**丙酸杆菌)进入手术部位的时间;(2)美国麻醉师学会(American Society of Anesthesiologists, ASA)评分:Shrestha等[11]研究发现ASA评分>2分与SSI发生率的增加有关,ASA评分是根据患者体质状况和对手术危险性进行分类系统;(3)社会和行为因素:Maradit等[12]通过研究发现在20124例髋关节和膝关节置换术中,吸烟与SSI风险显著增高相关。这项研究结果与一项系统性综述一致[13],该综述报道了吸烟者具有更高的感染、其他并发症和病死率风险。吸烟产生影响的机制是复杂的,而且并不总是很清楚;(4)糖尿病和应激性高血糖:糖尿病是围手术期高血糖的主要原因之一,文献报道[14-15]创伤患者合并糖尿病,SSI的发生率可达12%~20%。Richards等[16]通过前瞻性研究发现在骨科非糖尿病骨损伤患者中应激性高血糖与SSI存在显著的相关性。应激性高血糖通常是指疾病期间血糖升高。认识高血糖与感染性并发症之间的关系可能会显著影响骨科患者的预后。Zhang等[17]研究发现对于手术时间较长的糖尿病患者,术中增加一次预防性抗生素(头孢唑啉)的给药可能是预防SSI的独立保护因素,以减少SSI的发生。王艳华等[18]研究发现患者年龄、体重指数、手术时间、手术方式、手术部位与骨科手术患者SSI的发生有相关性( P >0.05),应积极采取有针对性的预防控制措施降低骨科手术患者SSI的发生。其他危险因素包括现有感染、血清白蛋白浓度低、年龄偏大、肥胖、皮肤消毒准备不足、以及继发于血管疾病或放射造成的缺血。
控制感染最重要方式是预防。对于骨科植入物手术,头孢菌素已被证明是有效的预防性抗生素,头孢唑啉作为第一代头孢菌素,这是一种广谱的、骨、软组织和肌肉浓度良好、快速的抗生素,可以作为预防性抗生素选择[1]。文献报道SSI患者中培养的微生物对头孢唑啉不敏感(12.8%),敏感的(87.2%)[19]。预防性抗生素的给药时间非常重要,在切口前1h内给药。一项循证医学综述显示,在长骨骨折手术固定中,单剂量抗生素预防是足够的,多剂量并不会降低SSI发生率[20]。美国骨科医生学会的指南只建议在手术时间超过抗生素半衰期的1~2倍时(头孢唑啉的半衰期为1.5~2.0h)重新给药[21]。对于骨科择期手术,预防SSI,我国已有临床指南[22]。首先分析SSI的危险因素:既往手术史或感染史、患者整体因素及并存疾病、身体其他部位存在活跃或潜在感染灶以及手术相关因素和手术切口部位因素等,然后采取术前措施:如纠正低蛋白血症、控制血糖、戒烟、术前运用抗生素等;术中措施:如加强手术室和人员管理、提高手术操作技术减少手术时间、注重切口缝合等;术后措施:如纠正术后贫血、低蛋白血症、监测血糖、术后预防性抗生素使用、切口管理等。
金属植入物常用于骨折的切开复位和内固定。随着抗生素预防的使用,骨折固定后SSI的发生率从8.3%下降到3.6%,因此在骨折手术前常规应用抗生素预防感染[23]。Bakhsheshian等[24]通过系统回顾和Meta分析证实了在脊柱手术部位使用万古霉素粉末有助于减少SSI的发生。然而,抗生素并不能代替对外科手术过程的细致关注,如果进行外科手术,应采取最严格的无菌预防措施,以尽量减少感染的发生[25]。
综上所述,骨科Ⅰ类切口SSI的主要病原菌为金黄色葡萄球菌,其次为阴沟肠杆菌。在药敏报告出来前,可以选用耐药率较低的抗生素如喹诺酮类联合利福平进行抗感染治疗,然后根据药敏结果及时调整。
参考文献



声明:此文内容及图片由供稿单位提供,仅供学习交流,不代表骨科在线观点。